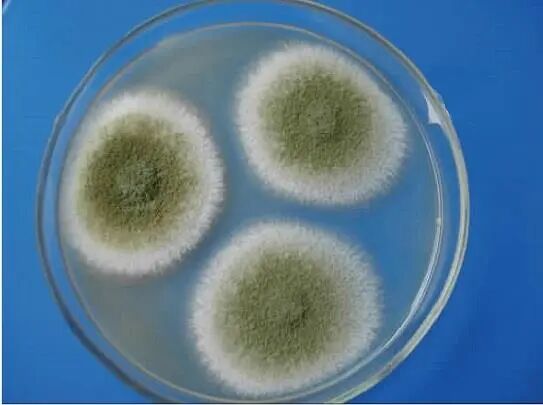
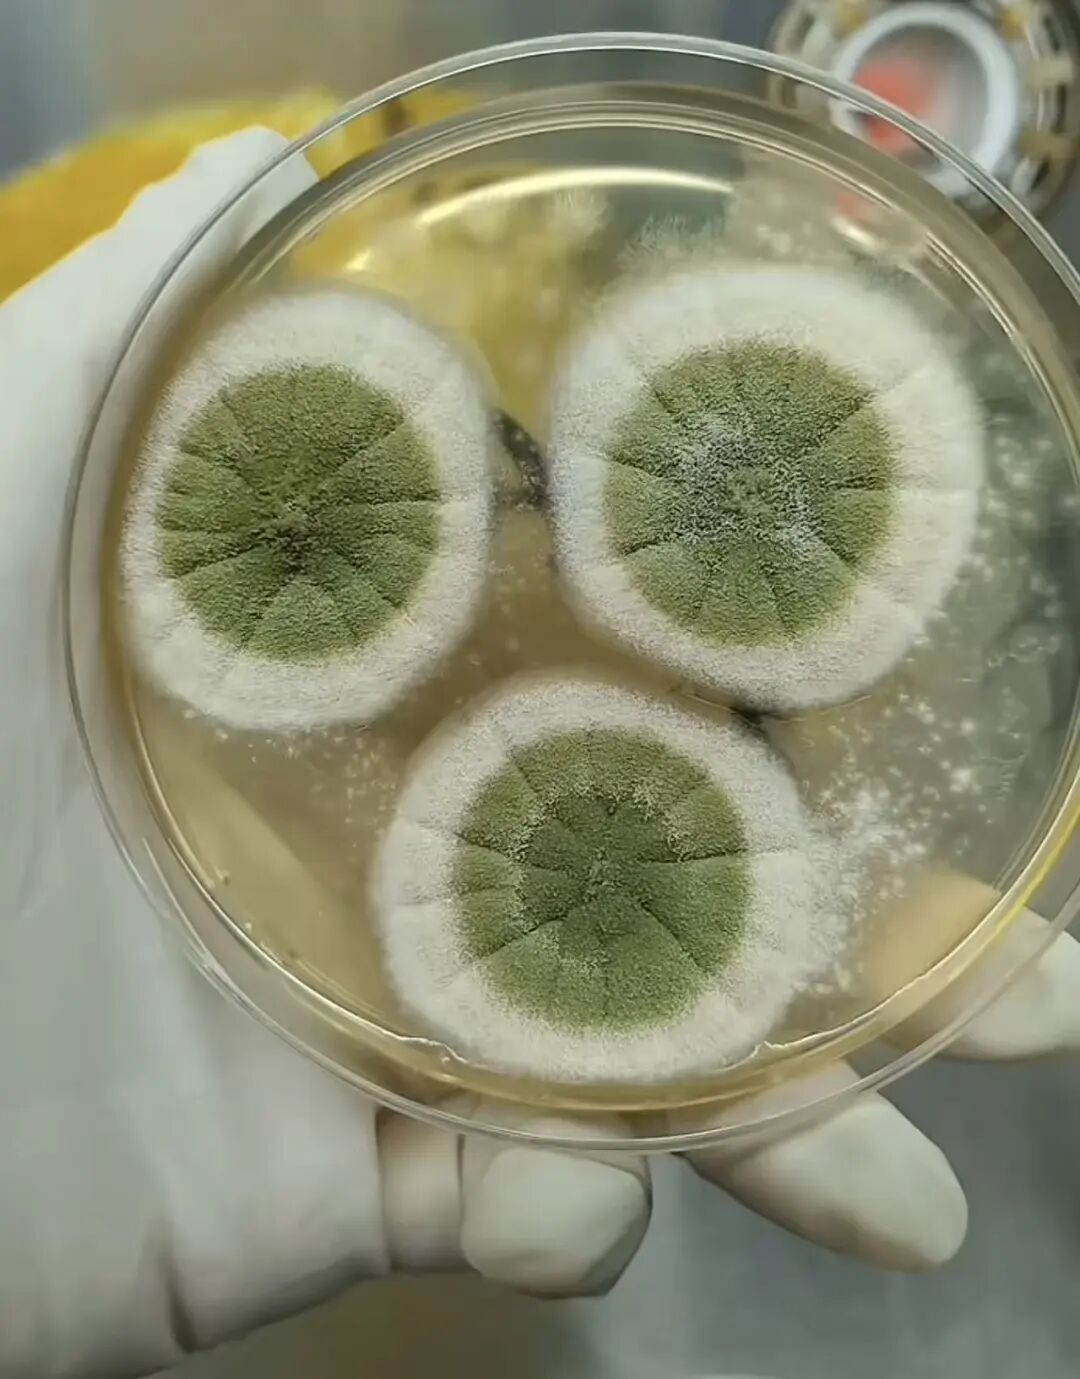

你知道吗?发酵就像给中药开了一场“量身定制”的魔法派对,核心秘诀就是“因材施酵”——得顺着每一味药材的“天生脾气”,挑选专属的微生物“小助手”,精准把控温度和湿度这两个“魔法开关”,让药材在自然的生物转化中,悄悄调整药性和功效,最终完美贴合临床治病的需求。
在中药发酵的“明星阵容”里,淡豆豉绝对是老牌经典选手。它的前身是平平无奇的黑豆,要蜕变成能入药的饮片,全程得靠曲霉型发酵工艺“修炼”。有趣的是,它和我们日常下饭的食用豆豉,虽说都出身黑豆“师门”,但一个是走“药用实力派”路线,一个是走“餐桌风味派”路线,发酵的“修炼秘籍”简直天差地别。
淡豆豉能不能修炼成合格的“良药”,最关键的一步就藏在前发酵阶段:必须用准那株核心菌株,还得有“火眼金睛”辨清相似曲霉的“真假美猴王”。比如米曲霉和黄曲霉长得像“双胞胎”,但米曲霉是帮淡豆豉转化成分的“好帮手”,黄曲霉却是会破坏药效甚至产生有害物质的“坏家伙”。要是这一步认错了“导师”,整个发酵过程就可能“走火入魔”——要么药性不足,要么产生杂菌,最终成不了能治病的合格淡豆豉。
中药淡豆豉是以黑豆为原料,搭配桑叶、青蒿为辅料制成的发酵饮片,临床主打解表、除烦,感冒寒热头痛、心里烦躁睡不着,都常用到它。它的发酵工艺一步都不能省,分为前发酵和密闭后发酵:先把桑叶、青蒿加水煮出汁,拌到净黑豆里让豆吸透汁水,再蒸透,完成原料熟化;接着用煮过的桑叶青蒿渣盖在黑豆上,闷着让它发酵,直到黑豆表面长满黄衣,这就是关键的曲霉型前发酵(有氧发酵);之后把发酵的黑豆取出来,洗掉药渣和菌丝体,再放进容器里密闭15到20天,让它充分发酵出香气(无氧发酵),最后略蒸、干燥,才算做好。全程温度30-35℃为佳,温度太低,不仅出不来该有的药用成分,发酵的香气也会不足,直接影响品质。

而我们平时做菜、佐餐吃的食用豆豉,虽然也是大豆发酵来的,但核心目的是做出好风味,发酵类型和中药淡豆豉的曲霉型发酵差别很大。川渝、陕南一带的毛霉型豆豉,用总状毛霉发酵,发酵完加盐、辣椒、香料调味,吃起来香辣浓郁,是家常必备的调味品;浙江、江西、岭南的曲霉型食用豆豉,虽也用曲霉发酵,但不用桑叶青蒿这些中药辅料和药用的淡豆豉完全是两回事;山东、河南还有黔桂等地的细菌型豆豉,靠枯草芽孢杆菌堆温发酵,周期短,成品会带点特殊的臭味,日本的纳豆,其实就是从这种细菌型豆豉演变来的。简单说,食用豆豉是为了好吃,中药淡豆豉是为了药用,发酵的菌株、步骤、要求都不一样,可不能混为一谈。



毛霉型发酵(毛豆腐发酵)曲霉型发酵(淡豆豉前发酵)细菌型发酵(纳豆)淡豆豉前发酵的核心,就是让曲霉在黑豆表面长黄衣,分解大豆的营养成分,为后续的药用成分转化打基础,这一阶段的唯一核心菌株是米曲霉,也是食品和中药发酵中公认的安全菌株。米曲霉菌落初期为白色,慢慢变得疏松并转为黄色,最后呈褐色至淡绿色,酶系丰富且活性适配黑豆的生物转化需求,发酵特性温和可控,能精准将黑豆成分转化为符合药用要求的物质,全程不会产生有害物质。
米曲霉但如果淡豆豉发酵工艺控制不好,很容易出现黑曲霉、黄曲霉的杂菌污染,其中黄曲霉产生的黄曲霉素更是一级致癌物,黑曲霉也存在安全风险,因此必须精准区分米曲霉与黑曲霉、黄曲霉的特性,从根源上避免杂菌混入,才能保证淡豆豉的发酵安全与药材品质。
黑曲霉的菌落整体偏小,生长过程中从白色过渡到鲜黄色,后期变为绒状黑色且呈放射状生长,虽产酶能力强,但并非淡豆豉发酵的合规菌株,一旦混入会造成杂菌污染,破坏药材有效成分。

黑曲霉黄曲霉的生长速度极快,菌落质地像羊毛或棉花状,部分呈颗粒状且有放射状沟纹,颜色从黄绿色过渡到棕绿色,其代谢产生的黄曲霉素具有强致癌性,是淡豆豉发酵中重点防控的杂菌,一旦出现会直接导致发酵失败,成品无法入药。
黄曲霉除了发酵工艺,中药淡豆豉和食用豆豉的特殊气味,来源也不一样,这也是二者发酵差异的直接体现。食用豆豉里,细菌型的臭味主要是枯草芽孢杆菌的代谢产物,毛霉型和曲霉型的香味,主要是菌株发酵加调味品的效果;而中药淡豆豉的那股特殊味道,不是枯草芽孢杆菌过度发酵导致的,而是发酵产生的有机酸、醇类,加上密闭后发酵中厌氧环境里少量杂菌的代谢,再加上黑豆里的含硫氨基酸分解出的硫化物,几样混在一起形成的,这反而是它发酵充分、成分转化到位的标志。
一颗普通黑豆摇身变成治病良药淡豆豉,背后藏着中药发酵的核心智慧——“因材施酵”:针对黑豆的特质,和追求风味的食用豆豉不同,淡豆豉的发酵全程以药用价值为核心导向。发酵师精准选定米曲霉作为核心“发酵主力”,再搭配桑叶、青蒿调和药性;通过分阶段调控温度、湿度等环境条件,让微生物与酶的每一步活动,都精准指向提升药用功效。其中的关键不仅是严格区分两者的发酵逻辑,更要精准辨别米曲霉与可能带来安全风险的黑曲霉、黄曲霉特性,做好全流程杂菌防控——这正是中药发酵“因药施艺、循规发酵”的核心准则。
唯有顺着药材的“性子”,选对发酵菌株、把控好每一个发酵细节,才能让中药发酵的魔力充分释放,让平凡的黑豆蜕变为能治病救人的药用良方。